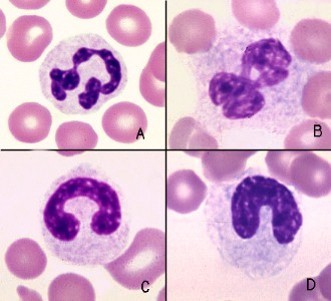
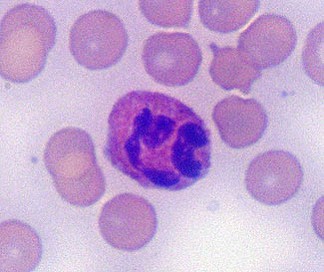

What are the parts of this blood test?

Red - Erython
Blue/white - Leukon
Blue - Thrombon
Green - Morphology
Where and what are the steps in neutrophil production?
- Bone Marrow
- Occasional EMH (spleen, liver, other)
- Myeloblast →Progranulocyte → Myelocyte →
- Proliferate and mature
- Metamyelocyte →Band →segmented neutrophil
- Maturation only
What are the 3 main steps in cells leaving blood vessels?
- Marginalisation
- Adhesion
- Migration
What may produce a shift from marginal to circulating pool?
- Epinephrine
- Infection
- Stress
What does a normal neutrophil count mean?
- Inflammatory disease is ruled out
- Inflammatory disease could be present
Name causes of neutrophilia
- Inflammation
- Infections (bacterial, viral, fungal, protozoal)
- Immune mediated anaemia
- Necrosis (including haemolysis, sterile inflam. and FB’s)
(Inflammatory mediators must be able to get from lesion to circulation to reach marrow – think about superficial skin, LUTD, CNS)
- Steroid
- Stress
- Steroid therapy (occ. ACTH)
- Hyperadrenocorticism
- Physiological
- Fight or flight (excitement, fear, pain, exercise)
- Chronic neutrophil leukaemia
- Paraneoplastic (rectal polyp, renal tubular carcinoma, metastatic fibrosarcoma)
- Other
- E.g. LAD
Name regenerative and degenerative causes of left shift neutrophilia
Regenerative left shift: mature neutrophils Hematology: neutrophil outnumber bands and are elevated or normal.
Degenerative left shift: excessive neutophil consumption → bands and/or less mature leukocytes outnumber mature neutrophils.
What causes a right shift of neutrophils?
•Glucocoticoids down-regulate adhesion molecules, less neutrophils leave the circulation to die, aged cells remain in circulation
What would be signs of toxic change in neutrophils?
- Foamy cytoplasm
- Dispersed organelles (not discrete –EDTA)
- Diffuse cytoplasmic basophilia
- Persistent of cytoplasmic RNA
- Incl segmented neutrophils
- Döhle bodies
- Focal blue-grey cytoplasmic structures (RER/RNA)
- Isolated finding in some healthy cats
- Asynchronus nuclear maturation
- Finely granular nuclear chromatin but in “segments”
Label
A.Normal mature Neutrophil
B.Toxic neutrophil
C.Normal Band Neutrophil
D.Toxic Band Neutrophil
Name the different types of neutrophil inclusions and what can cause these
- Bacterial
- Ehrlichia, Anaplasma
- Viral
- Canine distemper
- Protozoa
- Toxoplasma
- Hepatozoon
- Fungi
- Histoplasma
- Hereditary/metabolic
- Chediak-Higashi, Birman cat anomaly, mucopolysidosis,
What is this?
Rabbit heterophil
What is this?

Reptile heterophil
What is this?

Avian Heterophil
Define heterophil
Functionally equivalent to neutrophils, but granules stain red
Name inflammatory causes of neutropenia
- Peracute/overwhelming bacterial infections
- Canine and feline parvo-virus
Name causes for decreased production neutropaenia
- Infections: parvovirus, FeLV, toxoplasma
- Toxicity: chemotherapy, oestrogen, chloramphenicol (cats)
- Neoplasia: leukaemia, myelodysplastic, metastatic
- Marrow necrosis
- Myelofibrosis
Name rare causes for neutropenia (4)
•Immune mediated neutropenia, Chediak-Higashi, ayclic haematopoiesis in grey collies, canine hereditary neutropenia
What does it mean to have neutropenia in:
A) Dogs/cats?
B) Horses?
C) Cows?
A) Very severe lesion
B) Probable severe lesion
C)Neutropenia typical in inflammation regardless of severity
What animal are these WBC types?

A) Canine
B) Feline
C) Equine
D) Bovine
D) Reactive
E) Granular
What are the categories of lymphocyte inclusions and what can cause these?
- Functional
- Large granular lymphocytes
- Infectious
- Ehrlichia
- Distemper
- Metabolic
- Lysosomal storage diseases
What are causes of lymphocytosis?
- Physiological
- Catecholamine mediated via splenic contraction (especially cats)
- Chronic Inflammation
- Chronic antigenic stimulation
- May include reactive lymphocytes
- Usu with neutrophilia and/or monocytosis (±eosinophilia)
- Young animals and recent vaccination
- Lymphoproliferative disorder (incl FeLV, BLV)
- May be lymphopenia in lymphoma
- Hypoadrenocorticism
What can case lymphopenia?
- Stress/steroid
- Endogenous or exogenous glucocorticoid
- shifts lymphocytes out of circulation & lymphocytolysis
- Acute inflammation
- Bacterial, viral or endotoxaemia
- Migration to inflamed tissue and homing to LN’s
- Often with neutrophilia or neutropenia
- Correction of lymphopenia → better prognosis
- Loss of lymph
- Chylothorax (drainage) or lymphangiectasia
- Cytotoxic drugs, radiation
- Immunodeficiency syndrome
- Lymphoma
- LN pathology and disrupted circulation
What is seen with reactive lymphocytes?
- ↑ cytoplasm
- ↑ cytoplasmic basophilia
- Perinuclear halo
- Prominent Golgi zone
- ↑, eccentric, cleaved nucleus
- More medium and large (i.e., vs peripheral blood “small”)













